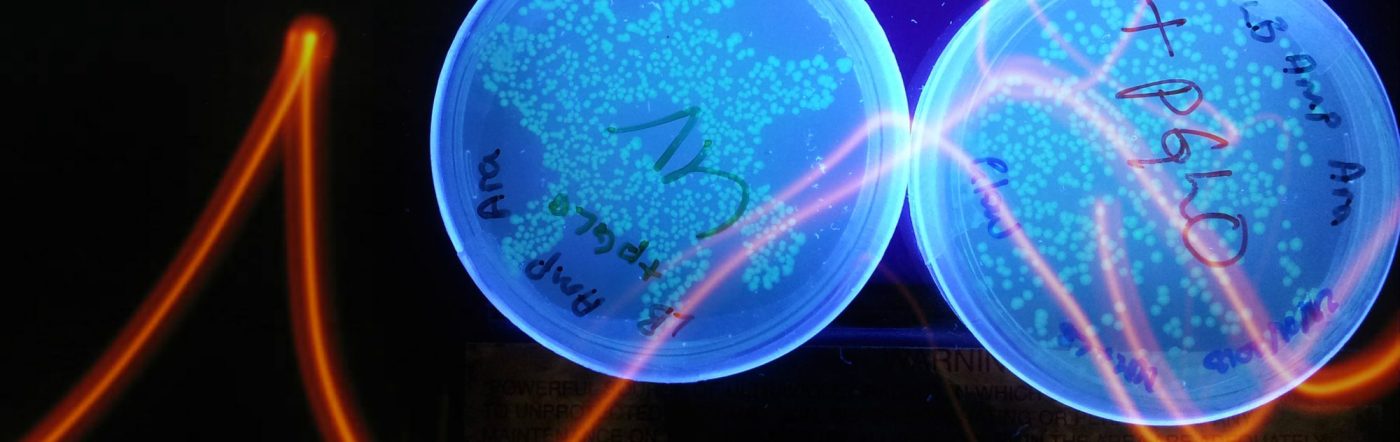

Uncontainable Life: A Biophilosophy of Bioart investigates the ways in which thinking through the contemporary hybrid artistico-scientific practices of bioart is a biophilosophical practice, one that contributes to a more nuanced understanding of life than we encounter in mainstream academic discourse. When examined from a Deleuzian feminist perspective and in dialogue with contemporary bioscience, bioartistic projects reveal the inadequacy of asking about life’s essence. They expose the enmeshment between the living and non-living, organic and inorganic, and, ultimately, life and death. Instead of examining the defining criteria of life, bioartistic practices explore and enact life as processual, differential, and always already uncontainable, thus transcending preconceived material and conceptual boundaries.
In this way, this doctoral thesis concentrates on the ontology of life as it emerges through the selected bioartworks: “semi-living” sculptures created by The Tissue Culture and Art Project and the performance May the Horse Live in Me (2011) by L’Art Orienté Objet. The hope is that such an ontology can enable future conceptualisations of an ethico-politics that avoids the anthropocentric logic dominant in the humanities and social sciences.
PhD project – date: 1 September 2011 – 22 April 2016
Monograph:
Radomska, M., 2016. Uncontainable Life: A Biophilosophy of Bioart [PhD dissertation]. Linköping: Linköping University Electronic Press. [OPEN ACCESS]